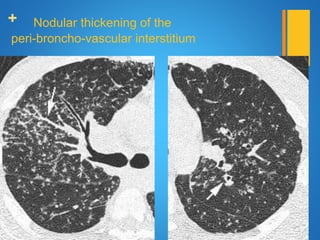
+ Nodular thickening of the
peri-broncho-vascular interstitium

This document provides information on sarcoidosis, a multisystem chronic inflammatory disease characterized by non-caseating granulomas. It discusses the epidemiology, etiology, clinical presentation, pathology, diagnosis and systems involvement of the disease. Sarcoidosis most commonly affects the lungs and lymph nodes, presenting as bilateral hilar lymphadenopathy. The cause is unknown but believed to involve a disordered immune response in genetically predisposed individuals. Diagnosis is based on clinical features along with identification of non-caseating granulomas in biopsy specimens.